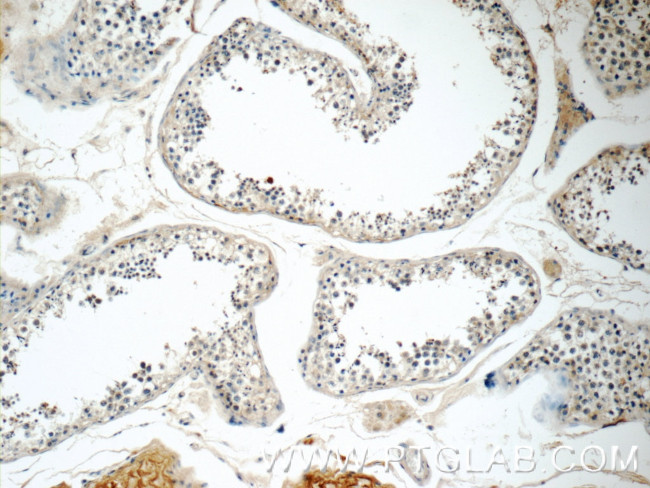
RGSL1 Antibody in Immunohistochemistry (Paraffin) (IHC (P))

Search
Proteintech
RGSL1 Polyclonal Antibody
{{$productOrderCtrl.translations['antibody.pdp.commerceCard.promotion.promotions']}}
{{$productOrderCtrl.translations['antibody.pdp.commerceCard.promotion.viewpromo']}}
{{$productOrderCtrl.translations['antibody.pdp.commerceCard.promotion.promocode']}}: {{promo.promoCode}} {{promo.promoTitle}} {{promo.promoDescription}}. {{$productOrderCtrl.translations['antibody.pdp.commerceCard.promotion.learnmore']}}
产品信息
25836-1-AP
种属反应
宿主/亚型
分类
类型
抗原
偶联物
形式
浓度
规格
纯化类型
保存液
内含物
保存条件
运输条件
产品详细信息
Immunogen sequence: MSSAEIIGS TNLIILLEDE VFADFFNTFL SLPVFGQTPF YTVENSQWSL WPEIPCNLIA KYKGLLTWLE KCRLPFFCKT NLCFHYILCQ EFISFIKSPE GGEELVDFWI LAENILSIDE MDLEVRDYYL SLLLMLRATH LQEGSRVVTL CNMNIKSLLN LSIWHPNQST TRREILSHMQ KVALFKLQSY WLPNFYTHTK MTMAKEEACH GLMQEYETRL YSVCYTHIGG LPLNMSIKKC HHFQKRYSSR KAKRKMWQLV DPDSWSLEMD LKPDAIGMPL QETCPQEKVV IQMPSLKMAS SKETRISSLE KDMHYAKISS MENKAKSHLH MEAPFETKVS THLRTVIPIV NHSSKM (1-355 aa encoded by B C142944)
仅用于科研。不用于诊断过程。未经明确授权不得转售。
篇参考文献 (0)
生物信息学
蛋白别名: GTPAse-activating protein; regulator of G-protein signaling 1; regulator of G-protein signaling like 2; Regulator of G-protein signaling protein-like; unnamed protein product
基因别名: 4930415K13Rik; Gm202; RGSL; RGSL1; RGSL2
UniProt ID: (Human) A5PLK6
Entrez Gene ID: (Human) 353299, (Mouse) 240816